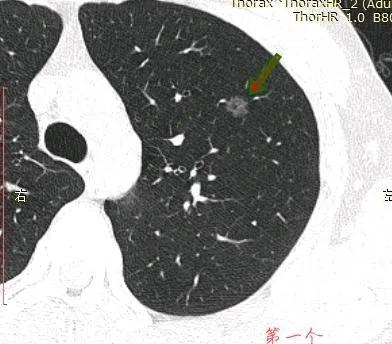
因癌症去世的妈妈,母亲肺癌子女查出磨玻璃结节
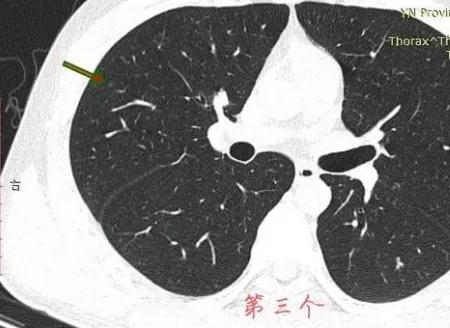
因癌症去世的妈妈,母亲肺癌子女查出磨玻璃结节

#生命摆渡人##我的2022##2022重庆头条#
这位云南的小伙子,21岁,因为发烧查出4个磨玻璃肺结节,贴吧向我求助后,我断定大的9mm磨玻璃结节结节已有危险,因为是初次发现,但还是要求按指南先随访排除炎症,哪怕10%的炎症或消掉的机会也不能放过。
因为患者有肺癌家族史,对肺癌恐惧极深,这种亲历的梦魇般的恐惧,站在岸上的其他人没办法理解。虽然在网上已咨询几次,但患者还是直接千里迢迢从云南跑过来找我面诊,希望得到一个更确定的诊断结果。仔细看了他带来的资料,我确定左肺9mm的结节已是微浸润腺癌,需要手术切除,但还是劝返,和言劝其先随访排除炎症,保证不耽误病情。
三个月后,患者再如约而至,复查高分辨率ct发现结节没有消失,考虑是微浸润腺癌。那也手术不犹豫,优先安排,楔形切除小手术搞定。术中和术后大病理都术前判断一模一样。
以下转自患者咨询:
2021-12-11
戴主任你好,慕名而来!我今年21岁,不抽烟,有家族肺癌史(我妈妈是肺腺癌过世),双肺多发磨玻璃结节。
我10月14号开始反复发烧半个月,吃布洛芬没用,吃对乙酰氨基酚片的话只能暂时退烧,最后在输液输莫西沙星氯化钠针水三天后痊愈。期间输了两天后隔了两天又输了一天。当时发现磨玻璃结节两个,询问急诊医生,医生建议我三个月复查。
在11月16号,自己担心去了一趟胸外科门诊,医生看了片子之后直接让我复查胸部平扫➕HRCT,看了复查片子之后医生问过我也没有家族史,随后医生说癌症可能性非常大,并且已经说到要手术和靶向药治疗。但还是让我吃半个月莫西沙星,由于当地拜复乐没买到,就吃了其他牌子的莫西沙西,最后网购吃了三颗拜复乐!距离复查只有一周,这个月以来一直焦虑。因为双肺足足有四个磨玻璃结节,在网上看到戴主任的专业,希望能够得到戴主任的建议,4个结节冷月都帮我截图了,我放在下面,麻烦戴主任帮我看看!

我的回复:
左肺的,已有事。右肺,没啥事。
2021-12-14
我今年21岁刚刚毕业,发烧时发现4个磨玻璃结节,最大的一个已经10×8mm。上次有辛得到你的回复,您判断为可能是恶性的结节。自从听你说完之后更加睡不好觉。目前也知道我难逃一刀的命运,但是很是希望能够去主任那面诊住院。家里面之前本就因为治疗妈妈肺腺癌花钱花了很多,现在我也可能是,不免有点后怕!手术技术方面我只相信主任!希望主任能够翻一翻我!
我的回复:
初次发现至少随访三个月排除炎症后,再来加号。
2021-12-29
今年我21岁,距离首次发现肺结节两个月左右,10月24日首次发现肺结节,11月16日去胸外科门诊,医生告知高危结节需要抗炎一个月后复查!期间得到您两次回复,告诉我大的结节已经有事,同时我加号请求您也说等抗炎结束再说!我昨天去复查,当时医生告诉我目前大的那个结节确定是恶性了需要立即手术,可能已经到浸润阶段!小的结节(结节三)感觉不太好,可能需要二次手术!
因为我目前年纪也还小且我妈妈就是肺腺癌过世,家里人知道打击很大!希望我能够得到最有效的治疗!特此希望主任判断三个结节各到什么阶段,同时希望主任同意加号,1月10的号。最好能够年前手术,很是害怕自己一下就嗝屁儿了,求求主任了!
我的回复:
左肺结节,至少微浸润腺癌。右侧结节良性的。
2022-01-10
不知道主任能否记得我,我是今天早上面诊云南昭通的一名患者,今年21岁,2个多月以前发现肺结节,期间一直不安。辗转多家医院均告知需要立即住院手术。也多次发帖询问主任,有幸得到主任回复,至少微浸润。至此很是希望能够得到主任手术,抢了几次号终于抢到今天早上的特需门诊号!
终于见到主任后,主任很耐心看完报告和光盘。结论跟之前一样,至少微!至于另外一个结节主任坚定说这个结节10年内不会有事。听到这句话真的很心安,这意味着我短时间内不用二次手术。
由于我比较年轻,主任希望更多的保住我的肺功能!也更希望我的是炎症,选择让我继续消炎一个疗程三个月后复查!有百分之十的几率是炎症,虽然之前吃过莫西沙星,但是不是拜复乐。我选择相信主任,准备回家以后好好休息等待复查。就算到手术,我相信我在主任的医治下也能治愈!
在此,很感谢主任的定心丸。家里人知道后也很高兴,表示下次复查要跟着一起来见见主任!还有这次见面有点紧张,我准备的书想让您签字也忘了。哈哈哈。
很幸运能够遇到主任,祝愿主任新年万事如意,身体健康。也祝愿贴吧里面的各位患者们好运连连,身体健康!
2022-04-12
有幸昨天得到主任面诊,诊断为微浸润,我选择立即手术。李满元医生也为我开了入院单,今天早上去办理了入院登记。现在就等着电话通知入院了。得到主任优先住院的机会,不过有一个疑问,我家是云南昭通的,常住于云南昆明。问过李医生,他表示差不多2周左右入院,目前有个疑问。如果今天我回云南昆明,在接到入院通知电话的时候再来重庆可以吗?听说到时候到重庆要一个礼拜才能住院,现在我人在车站。不知道怎么办,该回还是不该回!
我的回复:
一般7天左右优先安排入院,前面是做院前检查。
2022-05-18
感谢主任的精确判断,对结节性质真的做到了火眼金睛,去年本地医生告诉我需要化疗的时候,我人都傻了。我才22啊,就需要化疗,那我还有什么未来呢!
幸亏遇到主任,主任判断微,直接手术。术中病理果然是微,手术结束后还发短信告知家属,真的很温馨!目前我个人恢复得很不错,大病理报告也出来了。希望主任再帮忙看看,需不需要做后续治疗,基因检测有必要做吗。会不会有复发几率呀!谢谢主任,期待再次得到您的回应。

我的回复: 不需要任何后续治疗,手术即根治,几乎100%的自然寿命率。谢谢您对我诊断的信任及时手术。根治就是硬道理!